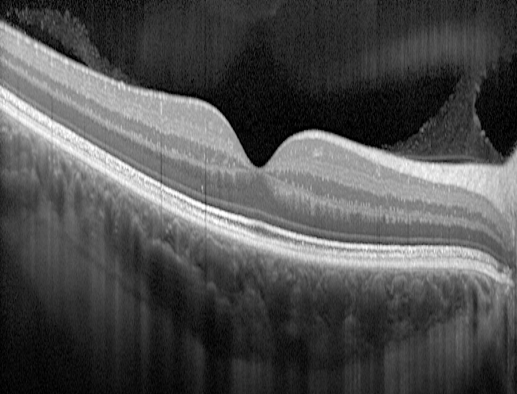
Image en coupe OCT d'une rétine normale
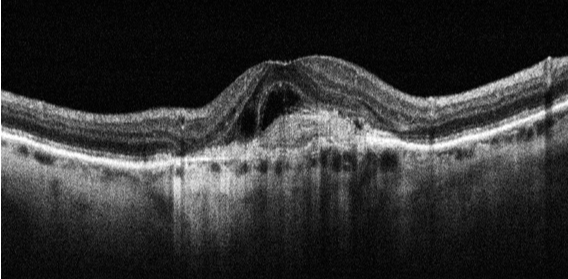
Image OCT d'une DMLA humide avec néovaisseaux choroïdiens

Notre Offre de Soins
Structure de soins spécialisée dans l'imagerie Ophtalmologique et dans la prise en charge des maladies rétiniennes
Le Centre Ophtalmologique Rabelais est une structure de soins spécialisée dans l'imagerie Ophtalmologique et dans la prise en charge médicale experte des maladies rétiniennes (DMLA, rétinopathie diabétique, occlusions veineuses).
La Photobiomodulation (PBM)
Traitement pour la dégénérescence maculaire liée à l'âge débutante et intermédiaire.
La photobiomodulation (PBM) aussi appelée luminothérapie, est une approche thérapeutique pour le traitement de différentes maladies rétiniennes et notamment la dégénérescence maculaire liée à l'âge débutante ou intermédiaire. Cette procédure thérapeutique a récemment obtenu l'approbation de la FDA (Food and Drug Administration) aux Etats Unis.
Elle consiste à l'utilisation d'une lumière diffuse proche de l'infra-rouge, de faible puissance, capable de « régénérer » les cellules de la rétine et notamment de l'épithélium pigmentaire, conduisant éventuellement à une amélioration du tableau clinique.
Le système utilisé Au Centre Ophtalmologique Rabelais est le VALEDA Air Light Delivery System. Le traitement est adressé aux patients présentant des drüsen séreux confluents, des décollements de l'épithélium pigmentaire drusénoïdes et des drüsen réticulés.
La procédure thérapeutique consiste en 3 séances sur 3 semaines réalisées à 1 jour d'intervalle. Les patients doivent avoir au moins 50 ans. La durée du traitement ne dépasse pas les 5 minutes.
Les résultats de la PBM consistent en un ralentissement de la formation de l'atrophie, une augmentation de l'acuité visuelle, une augmentation de la sensibilité aux contrastes ainsi qu'une réduction du volume occupé par les amas dégénératifs (drüsen).
Effets secondaires : aucun effet secondaire majeur n'a été enregistré, fait exception pour une vision floue et des troubles visuels temporaires essentiellement liés à l'éblouissement. Les troubles visuels sont normalement de courte durée et temporaires.
Prendre rendez-vous
Système Valeda — Photobiomodulation
Photothérapie Dynamique (PDT)
La Photothérapie Dynamique (PDT) à la Visudyne (vertéporfine) est un traitement oculaire consistant à administrer par voie intraveineuse un médicament photosensibilisant, puis à activer ce produit au niveau de la rétine grâce à un laser diode à lumière froide (689 nm).
Objectif : détruire sélectivement des néovaisseaux ou des zones d'hyperperméabilité choroïdienne, stabiliser l'acuité visuelle, et réduire l'œdème maculaire tout en préservant la rétine saine.
Principales indications :
- Choroïdopathie séreuse centrale (CSC) chronique
- Certains néovaisseaux choroïdiens (NVC atypiques)
- Choroïdopathie polypoïdale dans la pachychoroïde
Pour quels patients ? Patients présentant une CSC chronique persistante, un épanchement maculaire supérieur à 3 mois, une néovascularisation choroïdienne atypique, ou une intolérance / réponse insuffisante aux anti-VEGF.
Résultats attendus : Dans la CSC chronique, résorption du liquide sous-rétinien, gain ou stabilisation visuelle. Dans la néovascularisation choroïdienne, stabilisation de l'acuité visuelle et réduction de l'exsudation, avec possibilité de potentialisation par association aux anti-VEGF.
Nous Contacter
Imagerie rétinienne — PDT
L'injection intra-vitréenne (IVT)
L'injection intra-vitréenne (IVT) est un geste médical ophtalmologique qui consiste à injecter un médicament directement dans le vitré, la substance gélatineuse qui remplit l'intérieur de l'œil. Ce geste permet au traitement d'agir rapidement et efficacement sur la rétine.
L'IVT est utilisée pour traiter la dégénérescence maculaire liée à l'âge (DMLA) humide, l'œdème maculaire (diabète, occlusion veineuse), la rétinopathie diabétique, certaines infections intraoculaires et certains troubles inflammatoires de la rétine.
Les médicaments les plus couramment administrés sont les anti-VEGF et certains corticoïdes intraoculaires.
Recommandations après l'injection :
- Éviter de se frotter l'œil pendant 24–48 heures
- Ne pas se baigner le jour même
- Porter des lunettes de protection si nécessaire
- Poursuivre les collyres prescrits
- Contacter immédiatement votre ophtalmologiste en cas de symptôme inhabituel
Bénéfices attendus : stabilisation ou amélioration de la vision, réduction de l'œdème maculaire et contrôle de la prolifération anormale des vaisseaux rétiniens.

Fond d'œil rétinien
Angiographie Numérisée
L'Angiographie est un examen fondamental dans l'arbre décisionnel diagnostique des pathologies rétiniennes qui permet de visualiser les vaisseaux de la rétine à l'aide d'un colorant de contraste injecté par voie intraveineuse dans le bras.
L'angiographie peut être réalisée avec deux catégories de colorants, chacun possédant des spécificités :
Types de colorants :
- La Fluorescéine — colorant jaune, le plus couramment utilisé, qui met en évidence les petits vaisseaux irriguant la rétine
- Le Vert d'Indocyanine (ICG) — colorant vert utilisé pour visualiser le réseau vasculaire sous la rétine (choroïde)
Déroulement : Instillation de collyre pour dilater la pupille, installation confortablement assise, injection du colorant dans une veine du pli du coude, puis série de clichés minutés. Il faut prévoir au minimum 1h30 de présence.
Recommandations : Il est préférable de venir accompagné et de ne pas conduire après l'examen. Après la fluorescéine, la peau apparaît jaune orangé pendant plusieurs heures.

Angiographie — Néovaisseaux (DMLA)
OCT : Tomographie à Cohérence Optique
OCT Maculaire : La tomographie à cohérence optique est une technique d'imagerie non contact, non invasive et indolore permettant d'obtenir des images en coupes de la rétine dans toute son épaisseur. Son importante résolution permet d'obtenir une segmentation des différentes couches de la rétine et de quantifier l'épaisseur rétinienne.
OCT du Nerf Optique : L'OCT permet de mesurer l'épaisseur des fibres optiques et des couches ganglionnaires. L'examen est capable de dépister les signes précoces de souffrances du nerf optique dans les cas de glaucome débutant avant même l'apparition d'une détérioration du champ visuel.
On observe des pertes de 40 à 50% des cellules ganglionnaires avant une atteinte du champ visuel. L'irréversibilité de la perte des fibres associée au côté asymptomatique du glaucome renforce l'intérêt d'un dépistage précoce.
Déroulement côté patient :
- Dilatation des pupilles recommandée
- Examen en position assise, aucun contact avec vos yeux
- Tête installée dans une mentonnière, fixation d'une mire lumineuse
- Examen de quelques minutes, complètement indolore

Mire vue par le patient

Résultat OCT sur écran
OCT-Angiographie
C'est une nouvelle technique d'imagerie qui permet d'obtenir une projection en face de l'arbre vasculaire par l'analyse du déplacement des globules rouges dans les vaisseaux à partir de la technologie OCT. Le Centre Ophtalmologique Rabelais dispose de cet outil depuis son état prototype et a participé activement au développement de cette nouvelle investigation.
Avantage clé : l'OCT-Angiographie cartographie la vascularisation rétinienne sans injection de colorant, offrant un suivi régulier non invasif et indolore pour les patients atteints de DMLA, rétinopathie diabétique ou occlusions veineuses.
OCT — Rétine normale
OCT — DMLA humide (néovaisseaux)
Laser Maculaire
Le laser maculaire désigne l'utilisation d'un laser de faible puissance appliqué à la région maculaire pour traiter l'œdème maculaire, stabiliser la vision centrale et limiter l'hyperperméabilité vasculaire.
Indications :
- Œdème maculaire diabétique
- Œdème après occlusion veineuse rétinienne
- Fuites focales liées à des micro-anévrismes
- Choroïdopathie séreuse centrale (laser micropulsé)
Le laser micropulsé subseuil délivre l'énergie par trains très courts sans brûlure visible, préservant au mieux la macula centrale. Résultats évalués entre 6 et 12 semaines après la séance.

Appareil YAG
PPR (Laser Rétinien Périphérique)
Le laser rétinien périphérique utilise un laser photocoagulateur appliqué sur la rétine périphérique pour solidifier la rétine, traiter ou prévenir une déchirure, réduire les zones ischémiques et prévenir le décollement de rétine.
Objectif : générer une réaction thermique contrôlée afin de créer une cicatrice adhérente qui stabilise la rétine périphérique et empêche l'extension d'une déchirure ou d'un décollement débutant.
Indications principales :
- Déchirures rétiniennes en fer à cheval
- Prévention du décollement (myopie forte, antécédents)
- Traitement de zones ischémiques (rétinopathie diabétique)
- Consolidation après chirurgie ou vitrectomie
Résultats : Formation d'adhérences rétino-choroïdiennes en 7 à 15 jours, stabilisant la rétine et prévenant efficacement de nombreux décollements évolutifs.

Appareil YAG
SLT (Selective Laser Trabeculoplasty)
Le laser SLT est une technique utilisée pour traiter le glaucome à angle ouvert. C'est un laser non invasif et sélectif qui cible certaines cellules pigmentées du trabéculum afin d'améliorer l'écoulement de l'humeur aqueuse et de diminuer la pression intraoculaire.
La séance dure en moyenne 5 à 10 minutes, en consultation, sous anesthésie locale par collyre. Le patient repart le jour même.
Avantages :
- Traitement non invasif et généralement indolore
- Sans dommage permanent au trabéculum
- Peut être répété si nécessaire
- Possibilité de réduire ou arrêter certains collyres
- Résultat durable de 1 à 5 ans selon les patients
Résultats : Baisse de la pression intraoculaire de l'ordre de 20 à 30%, ce qui peut retarder ou éviter le recours à une chirurgie plus invasive.

Appareil YAG
Laser IP (Iridotomie Périphérique)
Le laser IP consiste à créer une micro-ouverture dans l'iris afin de permettre au liquide intraoculaire de circuler plus librement entre la chambre postérieure et la chambre antérieure de l'œil. C'est un traitement préventif ou curatif du glaucome par fermeture de l'angle.
Indications principales :
- Glaucome aigu par fermeture de l'angle
- Glaucome chronique par fermeture de l'angle
- Angles anatomiquement étroits
- Antécédents de glaucome aigu ou iris plateau
Le laser le plus employé est le Nd:YAG photodisruptif, parfois combiné avec un laser Argon thermique pour préparer un iris épaissi.
Résultats : Chute rapide de la pression intraoculaire, prévention des récidives et stabilisation du glaucome. L'orifice créé reste perméable à long terme.

Appareil YAG
Laser de Capsulotomie au YAG
La capsulotomie au laser YAG consiste à ouvrir la capsule postérieure du cristallin après chirurgie de la cataracte, lorsqu'elle s'est opacifiée (« cataracte secondaire »). Le laser YAG permet de restaurer la transparence sans recourir à une nouvelle chirurgie.
L'opacification survient généralement entre 6 mois et plusieurs années après l'intervention cataracte, responsable d'une baisse de vision, de vision floue, de halos ou d'éblouissements.
Résultats : L'amélioration visuelle est habituellement rapide (quelques heures à quelques jours), avec une vision plus nette et plus lumineuse. L'ouverture capsulaire est en général définitive et ne récidive pas.
Suites : Reprise des activités normales immédiate. Des collyres anti-inflammatoires peuvent être prescrits. Un contrôle est réalisé dans l'heure ou la journée.

Appareil YAG
Eyelight
Eyelight est un dispositif médical utilisant la lumière LED à haute intensité (photobiomodulation) pour traiter les troubles liés à la surface oculaire, en particulier la dysfonction des glandes de Meibomius (DGM), la sécheresse oculaire évaporative et certains états inflammatoires des paupières.
Indications principales :
- Sécheresse oculaire évaporative
- Dysfonction des glandes de Meibomius
- Blépharite postérieure
- Intolérance aux lentilles de contact
- Fatigue oculaire et sensation de grains de sable
Protocole : 4 séances espacées d'une semaine, puis des séances d'entretien une à deux fois par an. Traitement non invasif et indolore.

Glande lacrymale — Film lacrymal

Dispositif Eyelight — Centre Rabelais
Rétinographie & Angiographie Grand Champ
Rétinographie Couleur
La rétinographie couleur correspond à un cliché couleur du fond d'œil à un instant donné, permettant à l'ophtalmologiste de réaliser des comparaisons dans le temps. Rétinographie confocale avec angle de vue de 65°.
Rétinographie Grand Champ de 200°
Cette nouvelle technologie permet d'obtenir des clichés couleur du fond d'œil de 200° avec une visualisation d'une grande partie de la périphérie rétinienne de manière instantanée grâce à un miroir ellipsoïdal.
Un module angiographique est également disponible pour réaliser une imagerie plus étendue de l'état vasculaire de la périphérie rétinienne en comparaison avec les angiographies traditionnelles.

Optos — Grand champ 200°

Angiographie grand champ vs conventionnelle
Pachymétrie & Epi-Mapping
Pachymétrie : Examen qui permet de mesurer l'épaisseur totale de la cornée. Cette mesure est importante à considérer en regard des chiffres de tension oculaire car une cornée épaisse tend à surestimer les chiffres tensionnels, et inversement pour une cornée fine.
Epi-Mapping : Topographie d'épaisseur de l'épithélium cornéen. L'épithélium cornéen est connu pour sa capacité à moduler son épaisseur de manière compensatoire pour assurer un certain équilibre dans la biomécanique cornéenne.
La lecture de cette carte d'épaisseur est riche d'information sur les modifications cornéennes pathologiques, notamment dans le dépistage du kératocône où l'on observe un amincissement de l'épithélium en regard de la zone de déformation cornéenne.

Pachymétrie cornéenne

Epi-Mapping — Kératocône
Questions Fréquentes
Quels types de pathologies sont pris en charge au Centre ?+
Qu'est-ce que la photobiomodulation (PBM) et pour qui est-elle indiquée ?+
Comment se déroule une injection intravitréenne (IVT) ?+
Qu'est-ce qu'un OCT maculaire et pourquoi est-il important ?+
Quelle différence entre angiographie et OCT-Angiographie ?+
Qu'est-ce que la photothérapie dynamique (PDT) à la Visudyne ?+
Comment traite-t-on le glaucome au Centre Rabelais ?+
Quels équipements d'imagerie sont disponibles au Centre ?+
Prendre Rendez-vous
Pour toute demande de rendez-vous ou d'information complémentaire sur nos traitements, n'hésitez pas à nous contacter.
Demande de Rendez-vous